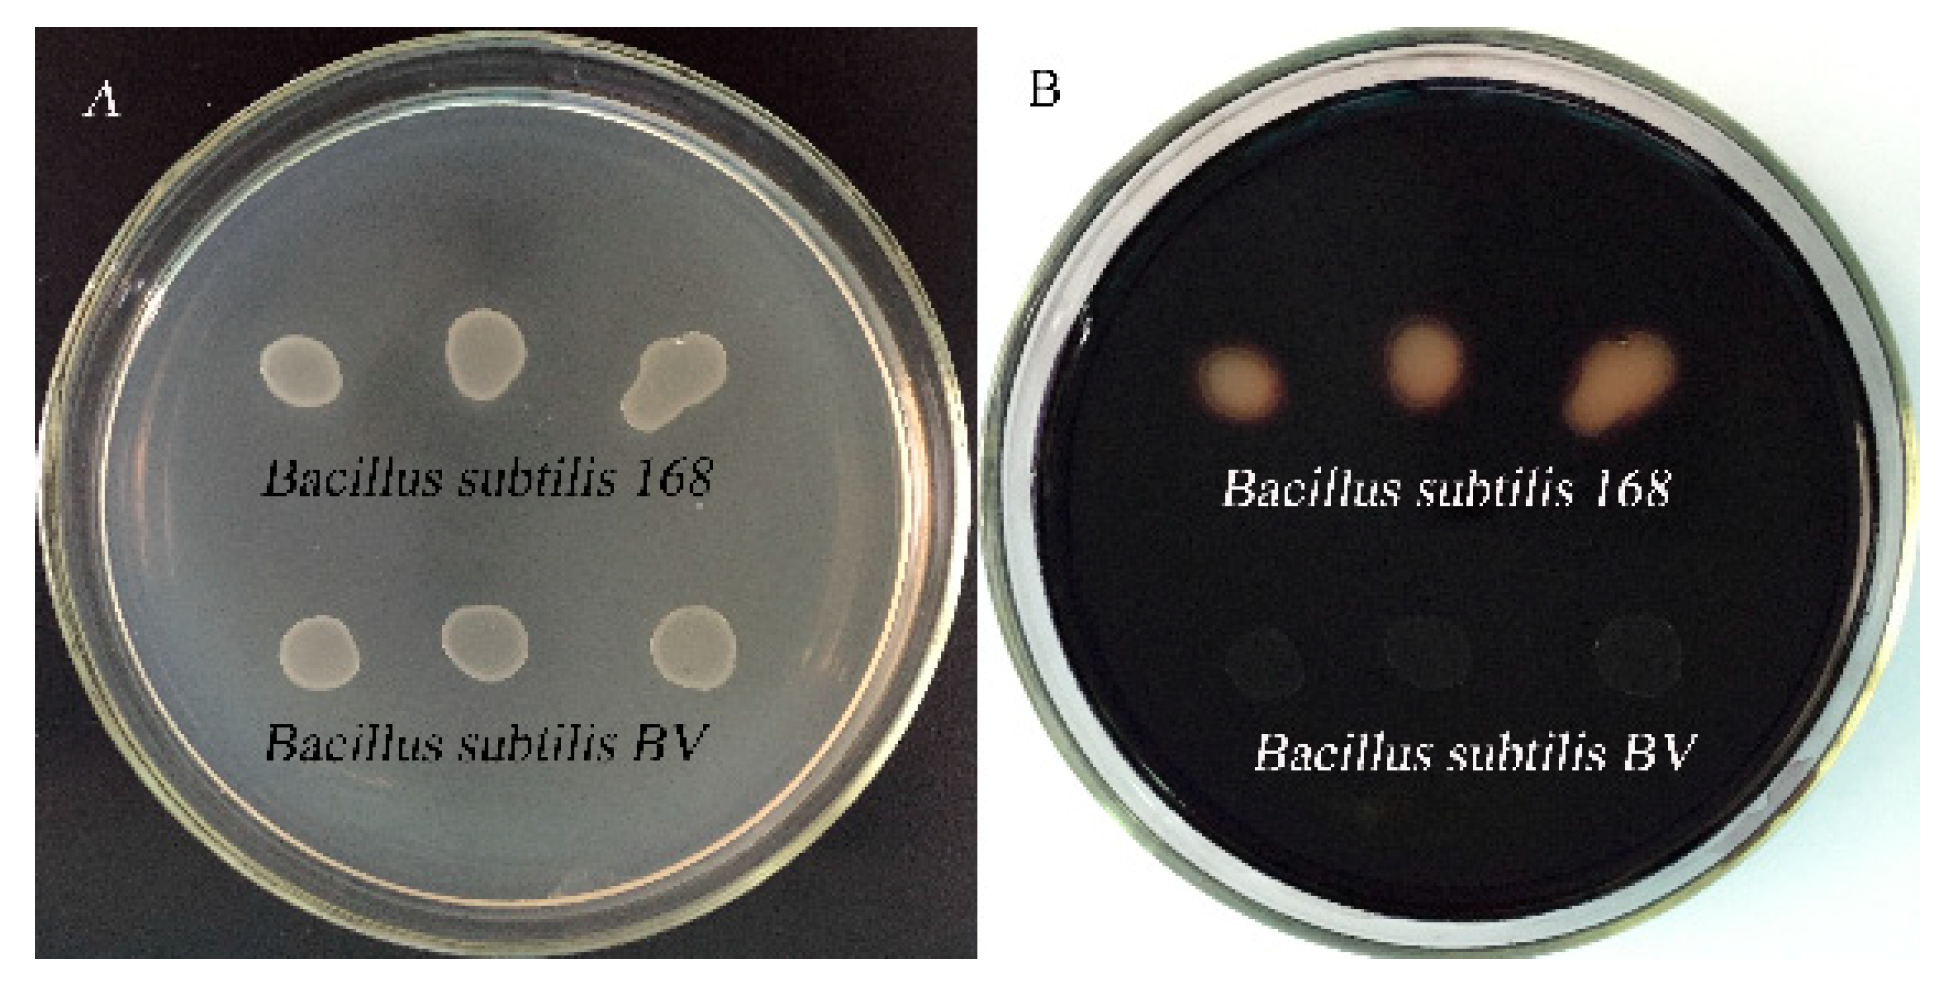
Molecules 24 03793 g005 Molecules 24 03793 g005

Surface Display of Antigen Protein VP8* of Porcine Rotavirus on Bacillus Subtilis Spores Using CotB as a Fusion Partner
Abstract
1. Introduction
2. Results
2.1. Expression of the VP8* Protein in Escherichia coli and the Antiserum
2.2. Construction of the Shuttle Vector pDG364-CotB-VP8*
2.3. Chromosomal Integration of Gene Fusion
2.4. Determination of Fusion Protein Expression on the B. Subtilis Spore Surface
2.5. Immunofluorescence Microscopy Analysis
2.6. Oral Delivery of the VP8* Protein Displayed on Spores Induced Serum and Mucosal Antibody Responses
3. Discussion
4. Materials and Methods
4.1. Plasmids, Strains, and Primers Sequences
4.2. Expression of the VP8* Protein in E. coli and Antiserum Production
4.3. Plasmids and Strain Construction
4.4. Preparation of Spores
4.5. Western Blot Analysis
4.6. Immunofluorescence Microscopy
4.7. Immunization of Mice and Sample Collection
4.8. ELISA of Specific Antibodies in Gut and Serum
4.9. Statistical Analysis
5. Conclusion
Author Contributions
Funding
Acknowledgments
Conflicts of Interest
References
- Anderson, E.J.; Weber, S.G. Rotavirus infection in adults. Lancet Infect. Dis. 2004, 4, 91–99. [Google Scholar] [CrossRef]
- Long, C.P.; McDonald, S.M. Rotavirus genome replication: Some assembly required. PLoS Path. 2017, 13, 6. [Google Scholar] [CrossRef] [PubMed]
- Paul, P.S.; Lyoo, Y.S. Immunogens of rotaviruses. Vet. Microbiol. 1993, 37, 299–317. [Google Scholar] [CrossRef]
- Matthijnssens, J.; Ciarlet, M.; Rahman, M.; Attoui, H.; Banyai, K.; Estes, M.K.; Gentsch, J.R.; Iturriza-Gomara, M.; Kirkwood, C.D.; Martella, V.; et al. Recommendations for the classification of group A rotaviruses using all 11 genomic RNA segments. Arch. Virol. 2008, 153, 1621–1629. [Google Scholar] [CrossRef]
- Matthijnssens, J.; Ciarlet, M.; McDonald, S.M.; Attoui, H.; Banyai, K.; Brister, J.R.; Buesa, J.; Esona, M.D.; Estes, M.K.; Gentsch, J.R.; et al. Uniformity of rotavirus strain nomenclature proposed by the Rotavirus Classification Working Group (RCWG). Arch. Virol. 2011, 156, 1397–1413. [Google Scholar] [CrossRef]
- Vlasova, A.N.; Amimo, J.O.; Saif, L.J. Porcine Rotaviruses: Epidemiology, Immune Responses and Control Strategies. Viruses-Basel 2017, 9, 27. [Google Scholar] [CrossRef]
- Yuan, L.; Saif, L.J. Induction of mucosal immune responses and protection against enteric viruses: Rotavirus infection of gnotobiotic pigs as a model. Vet. Immunol. Immunopathol. 2002, 87, 147–160. [Google Scholar] [CrossRef]
- Shao, L.; Fischer, D.D.; Kandasamy, S.; Rauf, A.; Langel, S.N.; Wentworth, D.E.; Stucker, K.M.; Halpin, R.A.; Lam, H.C.; Marthaler, D.; et al. Comparative In Vitro and In Vivo Studies of Porcine Rotavirus G9P 13 and Human Rotavirus Wa G1P 8. J. Virol. 2016, 90, 142–151. [Google Scholar] [CrossRef]
- Amimo, J.O.; Vlasova, A.N.; Saif, L.J. Detection and Genetic Diversity of Porcine Group A Rotaviruses in Historic (2004) and Recent (2011 and 2012) Swine Fecal Samples in Ohio: Predominance of the G9P 13 Genotype in Nursing Piglets. J. Clin. Microbiol. 2013, 51, 1142–1151. [Google Scholar] [CrossRef]
- Ramos, A.P.; Stefanelli, C.C.; Linhares, R.E.; de Brito, B.G.; Santos, N.; Gouvea, V.; de Cassia Lima, R.; Nozawa, C. The stability of porcine rotavirus in feces. Vet. Microbiol. 2000, 71, 1–8. [Google Scholar] [CrossRef]
- Wang, Y.H.; Azevedo, M.; Saif, L.J.; Gentsch, J.R.; Glass, R.I.; Jiang, B.M. Inactivated rotavirus vaccine induces protective immunity in gnotobiotic piglets. Vaccine 2010, 28, 5432–5436. [Google Scholar] [CrossRef] [PubMed]
- Zuffa, A. Stimulation of serum antibody formation in pigs by oral, subcutaneous or combined administration of live porcine rotaviruses or intramuscular inoculation of inactivated porcine rotaviruses in an oil adjuvant. Vet. Med. 1991, 36, 477–483. [Google Scholar]
- Wold, W.S.; Ison, M.G. Adenovirus. In Fields Virology 6th Edition; Lippincott, Williams & Wilkins: Philadelphia, PA, USA, 2013; pp. 1732–1767. [Google Scholar]
- Nishikawa, K.; Fukuhara, N.; Liprandi, F.; Green, K.; Kapikian, A.Z.; Chanock, R.M.; Gorziglia, M. VP4 protein of porcine rotavirus strain OSU expressed by a baculovirus recombinant induces neutralizing antibodies. Virology 1989, 173, 631–637. [Google Scholar] [CrossRef]
- Gil, M.T.; DE SOUZA, C.O.; ASENSI, M.; BUESA, J. Homotypic Protection Against Rotavirus-Induced Diarrhea in Infant Mice Breast-Fed by Dams Immunized with the Recombinant VP8* Subunit of the VP4 Capsid Protein. Viral Immunol. 2000, 13, 187–200. [Google Scholar] [CrossRef] [PubMed]
- Lentz, E.M.; Mozgovoj, M.V.; Bellido, D.; Santos, M.J.D.; Wigdorovitz, A.; Bravo-Almonacid, F.F. VP8*antigen produced in tobacco transplastomic plants confers protection against bovine rotavirus infection in a suckling mouse model. J. Biotechnol. 2011, 156, 100–107. [Google Scholar] [CrossRef]
- Blanchard, H.; Yu, X.; Coulson, B.S.; von Itzstein, M. Insight into host cell carbohydrate-recognition by human and porcine rotavirus from crystal structures of the virion spike associated carbohydrate-binding domain (VP8*). J. Mol. Biol. 2007, 367, 1215–1226. [Google Scholar] [CrossRef]
- Olmos, J.; Paniagua-Michel, J. Bacillus subtilis a potential probiotic bacterium to formulate functional feeds for aquaculture. J. Microb. Biochem. Technol. 2014, 6, 361–365. [Google Scholar] [CrossRef]
- Cutting, S.M. Bacillus probiotics. Food Microbiol. 2011, 28, 214–220. [Google Scholar] [CrossRef]
- Ciabattini, A.; Parigi, R.; Isticato, R.; Oggioni, M.R.; Pozzi, G. Oral priming of mice by recombinant spores of Bacillus subtilis. Vaccine 2004, 22, 4139–4143. [Google Scholar] [CrossRef]
- Barnes, A.G.C.; Cerovic, V.; Hobson, P.S.; Klavinskis, L.S. Bacillus subtilis spores: A novel microparticle adjuvant which can instruct a balanced Th1 and Th2 immune response to specific antigen. Eur. J. Immunol. 2007, 37, 1538–1547. [Google Scholar] [CrossRef]
- Rosales-Mendoza, S.; Angulo, C. Bacillus subtilis comes of age as a vaccine production host and delivery vehicle. Expert Rev. Vaccines 2015, 14, 1135–1148. [Google Scholar] [PubMed]
- Das, K.; Thomas, T.; Garnica, O.; Dhandayuthapani, S. Recombinant Bacillus subtilis spores for the delivery of Mycobacterium tuberculosis Ag85B-CFP10 secretory antigens. Tuberculosis 2016, 101, S18–S27. [Google Scholar] [CrossRef] [PubMed]
- Dai, X.X.; Liu, M.G.; Pan, K.C.; Yang, J.L. Surface display of OmpC of Salmonella serovar Pullorum on Bacillus subtilis spores. PLoS ONE 2018, 13, 11. [Google Scholar] [CrossRef] [PubMed]
- Iijima, H.; Takahashi, I.; Kiyono, H. Mucosal immune network in the gut for the control of infectious diseases. Rev. Med. Virol. 2001, 11, 117–133. [Google Scholar] [CrossRef] [PubMed]
- Cerutti, A.; Rescigno, M. The biology of intestinal immunoglobulin A responses. Immunity 2008, 28, 740–750. [Google Scholar] [CrossRef] [PubMed]
- Li, M.; Monaco, M.H.; Wang, M.; Comstock, S.S.; Kuhlenschmidt, T.B.; Fahey, G.C., Jr.; Miller, M.J.; Kuhlenschmidt, M.S.; Donovan, S.M. Human milk oligosaccharides shorten rotavirus-induced diarrhea and modulate piglet mucosal immunity and colonic microbiota. Isme J. 2014, 8, 1609–1620. [Google Scholar] [CrossRef] [PubMed]
- Wang, J.; Hu, G.; Gao, W.; Xu, L.; Ning, P.; Zhang, Y. Immortalized porcine intestinal epithelial cell cultures susceptible to porcine rotavirus infection. J. Virol. Methods 2014, 202, 87–94. [Google Scholar] [CrossRef]
- Lamichhane, A.; Azegami, T.; Kiyono, H. The mucosal immune system for vaccine development. Vaccine 2014, 32, 6711–6723. [Google Scholar] [CrossRef]
- Ramirez, J.E.V.; Sharpe, L.A.; Peppas, N.A. Current state and challenges in developing oral vaccines. Adv. Drug Del. Rev. 2017, 114, 116–131. [Google Scholar] [CrossRef]
- Isticato, R.; Ricca, E. Spore surface display. In The Bacterial Spore: From Molecules to Systems; American Society of Microbiology: Washington, DC, USA, 2016; pp. 351–366. [Google Scholar]
- Isticato, R.; Cangiano, G.; Tran, H.T.; Ciabattini, A.; Medaglini, D.; Oggioni, M.R.; De Felice, M.; Pozzi, G.; Ricca, E. Surface display of recombinant proteins on Bacillus subtilis spores. J. Bacteriol. 2001, 183, 6294–6301. [Google Scholar] [CrossRef]
- Mauriello, E.M.; Duc, L.H.; Isticato, R.; Cangiano, G.; Hong, H.A.; De Felice, M.; Ricca, E.; Cutting, S.M. Display of heterologous antigens on the Bacillus subtilis spore coat using CotC as a fusion partner. Vaccine 2004, 22, 1177–1187. [Google Scholar] [CrossRef] [PubMed]
- Kim, J.-H.; Lee, C.-S.; Kim, B.-G. Spore-displayed streptavidin: A live diagnostic tool in biotechnology. Biochem. Biophys. Res. Commun. 2005, 331, 210–214. [Google Scholar] [CrossRef] [PubMed]
- Hosseini-Abari, A.; Kim, B.-G.; Lee, S.-H.; Emtiazi, G.; Kim, W.; Kim, J.-H. Surface display of bacterial tyrosinase on spores of Bacillus subtilis using CotE as an anchor protein. J. Basic Microbiol. 2016, 56, 1331–1337. [Google Scholar] [CrossRef] [PubMed]
- Potot, S.; Serra, C.R.; Henriques, A.O.; Schyns, G. Display of Recombinant Proteins on Bacillus subtilis Spores, Using a Coat-Associated Enzyme as the Carrier. Appl. Environ. Microbiol. 2010, 76, 5926–5933. [Google Scholar] [CrossRef]
- Bernardeau, M.; Lehtinen, M.J.; Forssten, S.D.; Nurminen, P. Importance of the gastrointestinal life cycle of Bacillus for probiotic functionality. J. Food Sci. Technol. -Mysore 2017, 54, 2570–2584. [Google Scholar] [CrossRef]
- Huang, J.M.; La Ragione, R.M.; Nunez, A.; Cutting, S.M. Immunostimulatory activity of Bacillus spores. FEMS Immunol. Med. Microbiol. 2008, 53, 195–203. [Google Scholar] [CrossRef]
- Mou, C.; Zhu, L.; Xing, X.; Lin, J.; Yang, Q. Immune responses induced by recombinant Bacillus subtilis expressing the spike protein of transmissible gastroenteritis virus in pigs. Antivir. Res. 2016, 131, 74–84. [Google Scholar] [CrossRef]
- Amuguni, H.; Tzipori, S. Bacillus subtilis: A temperature resistant and needle free delivery system of immunogens. Hum. Vaccines Immunother. 2012, 8, 979–986. [Google Scholar] [CrossRef]
- Offit, P.; Clark, H. Protection against rotavirus-induced gastroenteritis in a murine model by passively acquired gastrointestinal but not circulating antibodies. J. Virol. 1985, 54, 58–64. [Google Scholar]
- Istrate, C.; Hinkula, J.; Charpilienne, A.; Poncet, D.; Cohen, J.; Svensson, L.; Johansen, K. Parenteral administration of RF 8-2/6/7 rotavirus-like particles in a one-dose regimen induce protective immunity in mice. Vaccine 2008, 26, 4594–4601. [Google Scholar] [CrossRef]
- Jiang, B.; Gentsch, J.R.; Glass, R.I. The role of serum antibodies in the protection against rotavirus disease: An overview. Clin. Infect. Dis. 2002, 34, 1351–1361. [Google Scholar] [CrossRef] [PubMed]
- Desselberger, U.; Huppertz, H.I. Immune Responses to Rotavirus Infection and Vaccination and Associated Correlates of Protection. J. Infect. Dis. 2011, 203, 188–195. [Google Scholar] [CrossRef] [PubMed]
- Moser, C.A.; Cookinham, S.; Coffin, S.E.; Clark, H.F.; Offit, P.A. Relative importance of rotavirus-specific effector and memory B cells in protection against challenge. J. Virol. 1998, 72, 1108–1114. [Google Scholar] [PubMed]
- Azevedo, M.S.P.; Yuan, L.; Iosef, C.; Chang, K.-O.; Kim, Y.; Nguyen, T.V.; Saif, L.J. Magnitude of serum and intestinal antibody responses induced by sequential replicating and nonreplicating rotavirus vaccines in gnotobiotic pigs and correlation with protection. Clin. Diagn. Lab. Immunol. 2004, 11, 12–20. [Google Scholar] [CrossRef] [PubMed]
- Glass, R.I.; Parashar, U.D.; Bresee, J.S.; Turcios, R.; Fischer, T.K.; Widdowson, M.-A.; Jiang, B.; Gentsch, J.R. Rotavirus vaccines: Current prospects and future challenges. Lancet (Lond. Engl.) 2006, 368, 323–332. [Google Scholar] [CrossRef]
- Papp, H.; Laszlo, B.; Jakab, F.; Ganesh, B.; De Grazia, S.; Matthijnssens, J.; Ciarlet, M.; Martella, V.; Banyai, K. Review of group A rotavirus strains reported in swine and cattle. Vet. Microbiol. 2013, 165, 190–199. [Google Scholar] [CrossRef]
- Wen, X.B.; Cao, D.J.; Jones, R.W.; Li, J.P.; Szu, S.S.; Hoshino, Y. Construction and characterization of human rotavirus recombinant VP8* subunit parenteral vaccine candidates. Vaccine 2012, 30, 6121–6126. [Google Scholar] [CrossRef]
- Wen, X.B.; Wei, X.M.; Ran, X.H.; Ni, H.B.; Cao, S.; Zhang, Y. Immunogenicity of porcine P6, P7-specific Delta VP8*rotavirus subunit vaccines with a tetanus toxoid universal T cell epitope. Vaccine 2015, 33, 4533–4539. [Google Scholar] [CrossRef]
- McNeal, M.M.; Sheridant, J.F.; Ward, R.L. Active protection against rotavirus infection of mice following intraperitoneal immunization. Virology 1992, 191, 150–157. [Google Scholar] [CrossRef]
- Köhler, E.; Antranikian, G. Covalent modification of proteins in Bacillus subtilis during the process of sporulation, germination and outgrowth. FEMS Microbiol. Lett. 1989, 57, 87–92. [Google Scholar] [CrossRef]
Sample Availability: Samples of the compounds (B. subtilis 168, pDG364-VP8*, pET32a-VP8*) are available from the authors. |

| Time | Group | ||||
|---|---|---|---|---|---|
| (d) | A | B | C | D | E |
| 0 | 0.1151 ± 0.0149 a | 0.1169 ± 0.0063 a | 0.1192 ± 0.006 a | 0.1132 ± 0.0087 a | 0.112 ± 0.0065 a |
| 14 | 0.1328 ± 0.014 B | 0.1164 ± 0.004 B | 0.1243 ± 0.0068 B | 0.2274 ± 0.0215 A | 0.1943 ± 0.029 A |
| 21 | 0.1343 ± 0.0168 B | 0.1246 ± 0.0058 B | 0.1338 ± 0.0147 B | 0.3765 ± 0.0513 A | 0.3294 ± 0.033 A |
| 28 | 0.1429 ± 0.0222 B | 0.1499 ± 0.0088 B | 0.1344 ± 0.0156 B | 0.427 ± 0.0493 A | 0.3849 ± 0.0247 A |
| 35 | 0.1541 ± 0.0169 B | 0.176 ± 0.0259 B | 0.1487 ± 0.0157 B | 0.5265 ± 0.021 A | 0.4766 ± 0.0314 A |
| Time | Group | ||||
|---|---|---|---|---|---|
| (d) | A | B | C | D | E |
| 0 | 0.1096 ± 0.0098 a | 0.1091 ± 0.0051 a | 0.1127 ± 0.0086 a | 0.1114 ± 0.005 a | 0.1149 ± 0.0045 a |
| 14 | 0.1208 ± 0.0091 B | 0.1328 ± 0.0099 B | 0.1252 ± 0.0082 B | 0.2285 ± 0.0311 A | 0.1839 ± 0.0105 A |
| 21 | 0.1297 ± 0.0035 B | 0.1428 ± 0.0086 B | 0.1402 ± 0.0108 B | 0.2628 ± 0.0048 Aa | 0.1942 ± 0.041 Ab |
| 28 | 0.1595 ± 0.0182 B | 0.1613 ± 0.0167 B | 0.1515 ± 0.011 B | 0.34 ± 0.0415 A | 0.3024 ± 0.0858 A |
| 35 | 0.1855 ± 0.0161 B | 0.1981 ± 0.0238 B | 0.188 ± 0.0111 B | 0.4521 ± 0.0195 Aa | 0.3295 ± 0.032 Ab |
| Strains, Plasmids, and Primer Sequences | Description | Reference or Restriction Site |
|---|---|---|
| Strains | ||
| Porcine rotavirus | Strain G5P[7] | Vico Biology |
| E. coli DH5α and Rosetta (DE3) | Type strain | Tiangen |
| B. subtilis 168 | Type strain | Bacillus Genetic Stock Center (BGSC) |
| B. subtilis BV | B. subtilis 168 amyE: CotB-VP8*, Cm r | This work |
| Plasmids | ||
| pET32a-VP8* | prokaryotic expression vector | Our lab |
| pDG364 | E.-coli–B.-subtilis shuttle vector | BGSC |
| pDG364-VP8* | pDG364 derivative carrying the VP8* gene | This work |
| pDG364-CotB-VP8* | pDG364 derivative carrying the fusion CotB-VP8* gene | This work |
| Primer sequences | ||
| VP8*-F a | 5′-CGCAAGCTTATGGCTTCGCTCATTTA-3′ | Hind I |
| VP8*-R b | 5′-CGGGAATTCTTATCTTGTGTGCACTATCTC-3′ | EcoR I |
| CotB-F | 5′-CGGGATCCACGGATTAGGCCGTTTGTCC-3′ | BamH I |
| CotB-R | 5′-GGGAAGCTTGGATGATTGATCATCTGAAG-3′ | Hind III |
| amyE-F | 5′-CCAATGAGGTTAAGAGTATTCC-3′ | null |
| amyE-R | 5′-CGAGAAGCTATCACCGCCCAGC-3′ | null |
| Groups | Strains | Method of Administration | Dose | Time of Administration | Time of Sample Collection |
|---|---|---|---|---|---|
| A | - | - | - | - | Days 0, 14, 21, 28, and 35 |
| B | B. subtilis 168 | Fed the mixed diet | 5.0 × 106 CFU/g | The whole period | Days 0, 14, 21, 28, and 35 |
| C | B. subtilis 168 | Gavage | 2.0 × 1010 CFU/mL | Days 1–3, 14–16, and 28–30 | Days 0, 14, 21, 28, and 35 |
| D | B. subtilis BV | Fed the mixed diet | 5.0 × 106 CFU/g | The whole period | Days 0, 14, 21, 28, and 35 |
| E | B. subtilis BV | Gavage | 2.0 × 1010 CFU/mL | Days 1–3, 14–16, and 28–30 | Days 0, 14, 21, 28, and 35 |
© 2019 by the authors. Licensee MDPI, Basel, Switzerland. This article is an open access article distributed under the terms and conditions of the Creative Commons Attribution (CC BY) license (http://creativecommons.org/licenses/by/4.0/).
Share and Cite
Li, W.; Feng, J.; Li, J.; Li, J.; Wang, Z.; Khalique, A.; Yang, M.; Ni, X.; Zeng, D.; Zhang, D.; et al. Surface Display of Antigen Protein VP8* of Porcine Rotavirus on Bacillus Subtilis Spores Using CotB as a Fusion Partner. Molecules 2019, 24, 3793. https://doi.org/10.3390/molecules24203793
Li W, Feng J, Li J, Li J, Wang Z, Khalique A, Yang M, Ni X, Zeng D, Zhang D, et al. Surface Display of Antigen Protein VP8* of Porcine Rotavirus on Bacillus Subtilis Spores Using CotB as a Fusion Partner. Molecules. 2019; 24(20):3793. https://doi.org/10.3390/molecules24203793
Chicago/Turabian StyleLi, Wanqiang, Jie Feng, Jiajun Li, Jianzhen Li, Zhenhua Wang, Abdul Khalique, Miao Yang, Xueqin Ni, Dong Zeng, Dongmei Zhang, and et al. 2019. "Surface Display of Antigen Protein VP8* of Porcine Rotavirus on Bacillus Subtilis Spores Using CotB as a Fusion Partner" Molecules 24, no. 20: 3793. https://doi.org/10.3390/molecules24203793
APA StyleLi, W., Feng, J., Li, J., Li, J., Wang, Z., Khalique, A., Yang, M., Ni, X., Zeng, D., Zhang, D., Jing, B., Luo, Q., & Pan, K. (2019). Surface Display of Antigen Protein VP8* of Porcine Rotavirus on Bacillus Subtilis Spores Using CotB as a Fusion Partner. Molecules, 24(20), 3793. https://doi.org/10.3390/molecules24203793






